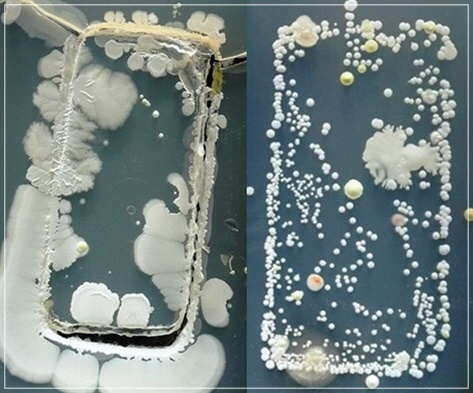

WHO가 코로나19에 대해 팬데믹 선언하며 코로나19에 대한 불안감이 방역에 관심이 높아지고 있습니다. 코로나19와 같은 바이러스는 마스크 착용과 손 씻기 '자가예방'을 더욱 강조하고 있습니다.


개인의 위생 뿐만 아니라 일상에서 계속 손이 닿는 스마트폰이나 노트북 IT 기기 관리도 중요한데 바이러스가 묻은 제품을 만지면 자가 예방접종도 허사가 되기 때문입니다.


일상생활에서 자주 사용하는 스마트폰과 IT 기기관리에 대한 소독 방법을 확인하시기 바랍니다.
바이러스의 온상 스마트폰
24시간 항상 곁에 두는 스마트폰은 바이러스 온상이 될 수 있습니다. 우리는 하루 평균 스마트폰을 약 2600번 정도 만지는 것으로 거의 손에서 떠나지 않는 스마트폰은 문손잡이, 엘리베이트 버튼, 공용 기기 등에 묻은 세균과 바이러스가 옮겨갈 수 있습니다.

물세척보다 소독제 사용해 닦아주기
세균은 스마트폰과 같이 딱딱한 표면에서 더 오래 생존하는 경향이 있는데 발열이 생겨 세균 번식에 유리합니다. 전문가들은 "코로나19 예방을 위해서는 손뿐만 아니라 생활용품 소독도 필요하다"며 "스마트폰 소독은 손 소독만큼 중요하다"고 강조합니다.


요즘 스마트폰들이 방수 기능있어 물로 씻는 이용자들이 많은데 아무리 방수 지원 스마트폰이라도 물 세척 방법은 그다지 좋은 소독 방법이 아닙니다. 전문가들은 물에 세척하기보다 소독제를 이용해 가볍게 닦아주는 것이 좋다고 권고합니다.
애플 기기관리 방침
최근 애플이 권장한 기기관리 지침 방법은 70% 이소프로필 알코올 물티슈나 클로락스(Clorox) 가정용 소독제 물티슈를 사용해 딱딱하고 구멍이 없는 표면을 닦아주면 된다고 합니다.


관련 클리너 제품은 국내 오픈마켓에서도 7000~1만 원 사이에 쉽게 구매할 수 있습니다.


알콜스왑 사용해 세척하기
위 제품 외에도 일반적으로 알려진 방법은 알콜스왑(알코올에 적셔진 솜) 천을 이용해 닦아주면 되는데 해당 제품은 온라인과 약국에서 구매할 수 있습니다. 또한 약국 등에서 5000원 안팎이면 살 수 있습니다.
스마트폰 소독 금지금지 약품
다만 에어로졸 스프레이, 암모니아, 유리 클리너, 과산화수소, 표백제, 압축 공기, 연마제 등은 기기 표면에 손상을 일으킬 수 있으므로 금지합니다.